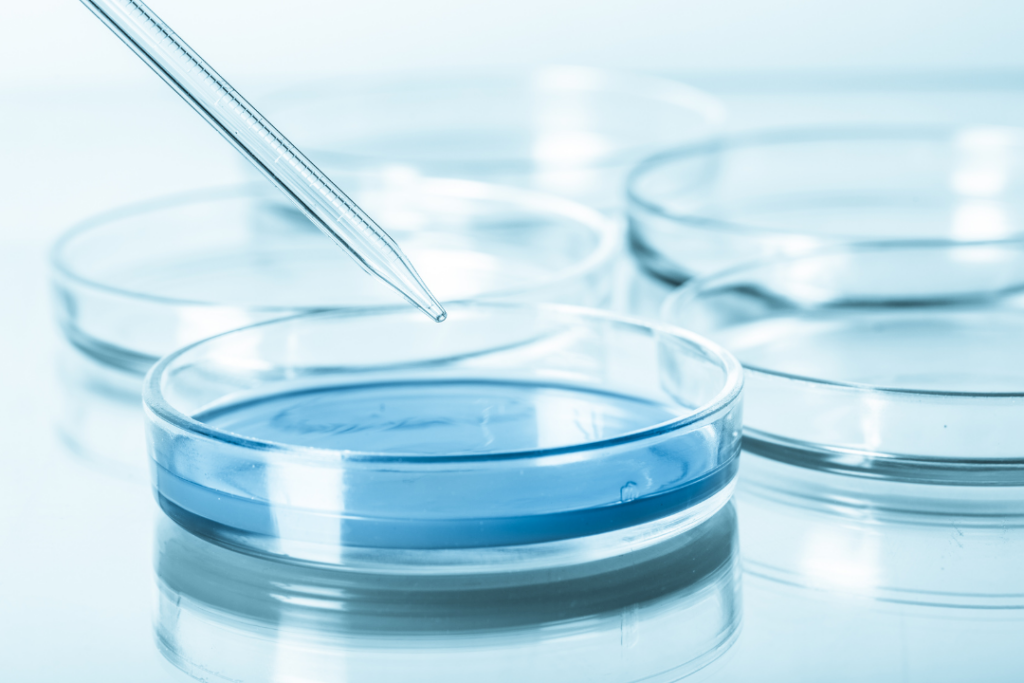

Come potabilizzare l’acqua del pozzo
| 6 Settembre 2023Come potabilizzare l’acqua del pozzo
Ultimamente stiamo ricevendo diverse richieste sul trattamento acque a livello domestico e industriale.
Di fatto ci troviamo in un periodo dove scarseggia l’acqua e le piogge sono sempre meno frequenti.
Per questo le famiglie e aziende vogliono approfittare dell’acqua di pozzo, che però dovuta alla sua scarsa qualità, hanno bisogno di un sistema di filtrazione completo.
Quando si parla di potabilizzazione dell’acqua di pozzo, ci riferiamo a un processo attraverso il quale si rende sicura e adatta al consumo umano l’acqua proveniente da uno dei principali serbatoi naturali presenti nel sottosuolo: il pozzo.
L’acqua di pozzo può essere un’ottima fonte di approvvigionamento idrico, ma può anche essere contaminata da una serie di sostanze nocive come batteri, virus, sostanze chimiche, pesticidi e metalli pesanti. La potabilizzazione serve quindi a rimuovere o ridurre al minimo queste impurità in modo da rendere l’acqua sicura per la salute umana.
Esistono diversi metodi e tecnologie utilizzate per potabilizzare l’acqua di pozzo. Uno dei più comuni è il trattamento di filtrazione. Durante questo processo, l’acqua passa attraverso una serie di filtri per rimuovere le particelle solide, come sabbia, limo e altri sedimenti. Questo aiuta a migliorare l’aspetto e il sapore dell’acqua, ma non è sufficiente per eliminare completamente i microorganismi nocivi.
Per garantire la completa sicurezza dell’acqua di pozzo, è essenziale utilizzare altri metodi come la disinfezione. Uno dei più comuni è l’utilizzo di cloro o altri disinfettanti per uccidere batteri, virus e altri agenti patogeni presenti nell’acqua. Questo processo è molto efficace e viene utilizzato a livello industriale nella produzione di acqua potabile.
In alcuni casi, la potabilizzazione dell’acqua di pozzo richiede anche l’utilizzo di altri trattamenti, come la rimozione di sostanze chimiche o metalli pesanti. Questi possono essere rimossi attraverso l’utilizzo di filtri speciali o additivi chimici che legano e trascinano queste impurità fuori dall’acqua.
È importante notare che la potabilizzazione dell’acqua di pozzo è un processo complesso e richiede l’impiego di professionisti qualificati per garantire risultati sicuri ed efficaci. È fondamentale seguire le linee guida e gli standard di qualità dell’acqua stabiliti dalle autorità competenti per assicurarsi che l’acqua di pozzo trattata sia sicura da bere.
La potabilizzazione dell’acqua di pozzo è un passo vitale per garantire l’accesso a un’acqua sicura e di qualità. È fondamentale investire nella manutenzione e nel monitoraggio regolare dei pozzi per garantire che siano sempre in condizioni ottimali e che l’acqua prodotta sia sicura per il consumo umano.
Vediamo quali sono i vantaggi di potabilizzare l’acqua del pozzo:
- Sicurezza per la salute: la potabilizzazione assicura che l’acqua sia sicura da bere, eliminando batteri, virus, parassiti e altre potenziali fonti di malattie.
- Qualità dell’acqua migliorata: il processo di potabilizzazione riduce i livelli di impurità e sostanze chimiche nocive nell’acqua, rendendola più pulita e di migliore qualità.
- Gusto e odore migliorati: la potabilizzazione può aiutare a rimuovere odori e sapori sgradevoli dell’acqua, garantendo un’esperienza di consumo più gradevole.
- Riduzione dei rischi ambientali: potabilizzare l’acqua del pozzo può aiutare a ridurre il rischio di contaminazione del suolo e delle falde acquifere circostanti, evitando la dispersione di sostanze tossiche o inquinanti.
- Risparmio sui costi: potabilizzare l’acqua del pozzo può ridurre la dipendenza dalle fonti di acqua in bottiglia o altre forme di approvvigionamento, permettendo risparmi a lungo termine.
- Sostenibilità: la potabilizzazione dell’acqua del pozzo può contribuire a una gestione sostenibile delle risorse idriche locali, riducendo la necessità di estrarre acqua da altre fonti o utilizzando risorse idriche limitate.
Soluzioni:
Noi possiamo offrire soluzioni personalizzate in base al tipo di acqua e al tipo di struttura, casa singola, condominio, hotel, ristorante, in base al risultato dei test dell’acqua possiamo inviare i dati direttamente in fabbrica e farci arrivare un kit per potabilizzare l’acqua completamente personalizzato e già tarato da tecnici professionisti del settore, solo da installare.
Ecco alcune caratteristiche importanti dei nostri kit:
- Kit completamente automatici.
- Parametri modificabili, se necessario.
- Vengono consegnati completamente programmati dalla fabbrica, secondo le esigenze del cliente.
- Manutenzione annuale facile ed economica.
- Kit altamente professionali, sia per il domestico che per l’industriale.
- Display LCD multilingue e di facile utilizzo.
- Tutti i prodotti sono altamente certificati per la potabilizzazione dell’acqua.
Se anche tu possiedi un pozzo e vuoi rendere l’acqua potabile compila il modulo e allega le analisi chimiche – fisiche della tua acqua, in base ai risultati possiamo prepararti un preventivo personalizzato.
Chi fa le analisi dell’acqua?:
L’analisi dell’acqua compete all’Azienza Sanitaria Locale (ASL). La richiesta di verifica dei parametri chimici e batteriologici, va dunque inoltrata alla ASL territorialmente competente.
Convenzioni a carattere locale possono talvolta coinvolgere nel processo analitico i laboratori dell’Agenzia Regionale per la Protezione dell’Ambiente ARPA ma il titolare del procedimento rimane l’ASL.
Quanto costa fare analizzare l’acqua?:
Il costo delle analisi di acqua per singolo campione dipende dal numero dei parametri analizzati e dai metodi analitici eseguiti . Solitamente il prezzo parte dalle 240 euro in su.
Analisi in farmacia
Esistono anche farmacie che effettuano le analisi dell’acqua, il costo parte da 40 euro in su, dipende da quanti e dai valori da controllare.
Per un preventivo più preciso, possiamo consigliare, le analisi di ASL perché controllano tutti i valori essenziali per la corretta potabilizzazione.